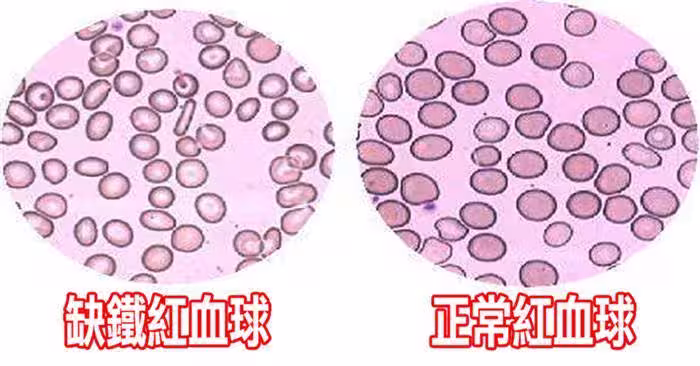

6/6
下一頁
他睡覺總覺得「雙腿有螞蟻在爬」掀開棉被卻都沒看到,直到去醫院才發現他罹患了...嚇到雙腿發軟
6/6
邱昕介紹,「不安腿綜合症」大多發生於50歲以上的中老年人,其中以女性比較常見。據相關數據顯示,其發病率高達5%-10%,隨著年齡增長,發病率呈現出增高趨勢。如果一安靜下來就有坐立難安的感覺或是半夜睡不著非要下床走走,這種不適感覺好像來自小腿深處,就要當心中招。
「一些患者得了不安腿綜合徵,有可能是帕金森前兆。
」邱昕說,「不安腿綜合症」只要能及早確診,並及時服用對症藥物,症狀很快就會得到緩解。在日常生活中要注意少喝咖啡及含咖啡因的飲料,並戒煙限酒。
「一些患者得了不安腿綜合徵,有可能是帕金森前兆。
」邱昕說,「不安腿綜合症」只要能及早確診,並及時服用對症藥物,症狀很快就會得到緩解。在日常生活中要注意少喝咖啡及含咖啡因的飲料,並戒煙限酒。
 呂純弘 • 115K次觀看
呂純弘 • 115K次觀看 呂純弘 • 217K次觀看
呂純弘 • 217K次觀看 呂純弘 • 9K次觀看
呂純弘 • 9K次觀看 呂純弘 • 47K次觀看
呂純弘 • 47K次觀看 呂純弘 • 7K次觀看
呂純弘 • 7K次觀看 花峰婉 • 6K次觀看
花峰婉 • 6K次觀看 呂純弘 • 10K次觀看
呂純弘 • 10K次觀看 舒黛葉 • 11K次觀看
舒黛葉 • 11K次觀看 呂純弘 • 8K次觀看
呂純弘 • 8K次觀看 呂純弘 • 39K次觀看
呂純弘 • 39K次觀看 呂純弘 • 13K次觀看
呂純弘 • 13K次觀看 呂純弘 • 11K次觀看
呂純弘 • 11K次觀看 呂純弘 • 4K次觀看
呂純弘 • 4K次觀看 呂純弘 • 6K次觀看
呂純弘 • 6K次觀看 奚芝厚 • 8K次觀看
奚芝厚 • 8K次觀看 呂純弘 • 19K次觀看
呂純弘 • 19K次觀看 舒黛葉 • 3K次觀看
舒黛葉 • 3K次觀看 喬峰傳 • 5K次觀看
喬峰傳 • 5K次觀看 舒黛葉 • 8K次觀看
舒黛葉 • 8K次觀看 呂純弘 • 41K次觀看
呂純弘 • 41K次觀看 呂純弘 • 11K次觀看
呂純弘 • 11K次觀看 呂純弘 • 4K次觀看
呂純弘 • 4K次觀看 呂純弘 • 8K次觀看
呂純弘 • 8K次觀看 呂純弘 • 22K次觀看
呂純弘 • 22K次觀看






















